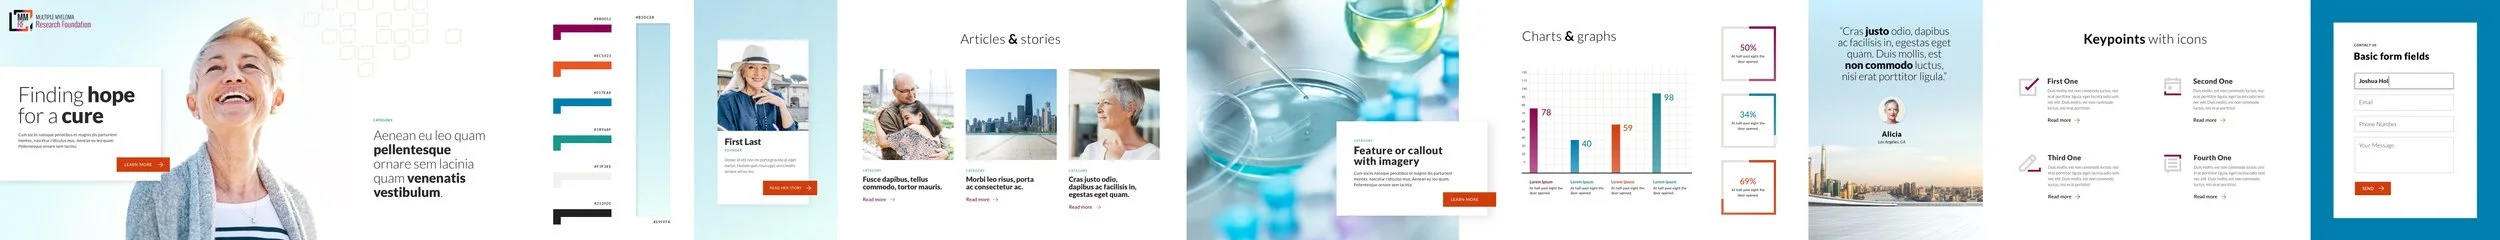

theMMRF.org
Transforming a Data-Driven Mission into a Patient-Centric Brand
the overview
The Multiple Myeloma Research Foundation (MMRF) is the largest nonprofit organization in the world dedicated to curing this blood cancer. To advance its mission, the MMRF needed a bolder, patient-focused brand that could drive engagement, collect valuable patient data, and ultimately help identify the right treatment options for patients. By repositioning the MMRF from a data-focused organization to a patient-centric leader, we helped redefine their brand, culminating in a website that became the new standard for their identity and impact.
the problem
Despite their established presence in the industry, the MMRF’s existing brand and digital presence lacked the boldness and emotional resonance needed to connect deeply with patients. The organization needed to:
Shift from a data-centric to a patient-centric narrative.
Position itself as an empathetic partner for patients while maintaining credibility as an industry leader.
Create a modern, approachable digital experience that could better support patient engagement and data collection.
The challenge was to craft a visual and verbal identity that balanced the organization’s expertise with the compassion needed to truly resonate with the myeloma community.
the solution
We began with a deep understanding of the patient journey, conducting extensive research, including patient and physician focus groups, ethnographic studies, and usability testing. These insights helped create detailed patient profiles, validate key drivers of engagement, and map the patient journey—foundational elements that informed every step of the project.
Through collaborative working sessions with the MMRF team, we developed a content strategy and website structure designed to tell the right story. Every element of the site mapped back to the patient journey and brand goals, ensuring a cohesive and engaging experience.
To elevate the brand, we provided a comprehensive visual facelift. Using stylescapes, we presented three visual concepts, each reflecting a different potential evolution for the MMRF brand. The chosen direction struck a balance between the organization’s current state and its aspirations, taking a thoughtful, patient-first step forward.
The resulting visual identity included custom iconography and illustrations to organize information and create a positive tone. The bold, modern design set the stage for the new website, which became a true standard-bearer for the MMRF brand. This digital-led transformation extended beyond the website, redefining the organization’s collateral and campaigns to align with the new look and feel.
the result
The redesigned website not only elevated the MMRF’s digital presence but also set a new standard for their brand, positioning the organization as a leader in patient-centric care and innovation. Key outcomes included:
The website became the new brand standard, guiding collateral and campaign updates.
Recognition from multiple industry awards, including:
2021 Horizon Awards: Gold, Health / Human Services Websites.
2021 WebAward Competition: Website Development.
2022 Hermes Creative Awards: Gold, Medical / Healthcare.
The new website successfully bridged the gap between the MMRF’s data-driven mission and its patient-first aspirations, empowering patients with information, fostering trust, and reinforcing the organization’s role as a leader in the fight against multiple myeloma.
the team
Creative Director: Jeff Abbott
Art Director/UI Designer: Aline Forastieri
UX Designer: Sheila Mullings
Content Strategist: Ky Krebsbach
Brand Strategist: Lauren Papes



Client workshop
MMRF Sitemap

Stylescapes (creative concepts)









Custom iconography


2021 Horizon Awards
Multiple Myeloma Research Foundation Website: Gold, Health / Human Services Websites
2021 WebAward Competition
Website Development
2022 Hermes Creative Awards
Gold, Medical / Healthcare